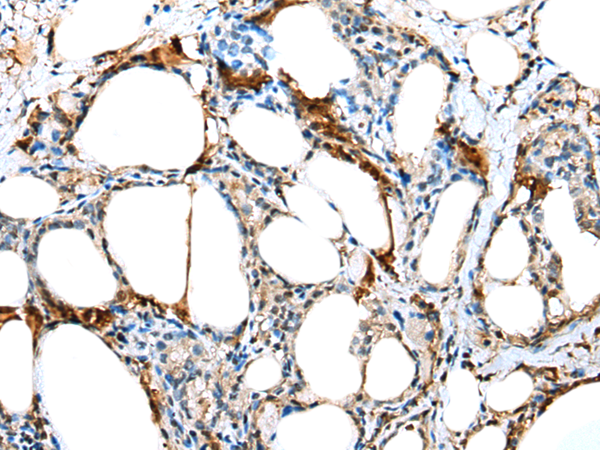

|
Background: |
Dyneins are multi-subunit, high molecular weight ATPases that interact with microtubules to generate force by converting the chemical energy of ATP into the mechanical energy of movement. Cytoplasmic or axonemal Dynein is an approximately 12 subunit complex of two heavy chains, two intermediate chains to anchor Dynein to its cargo, four smaller intermediate chains and several light chains. It performs functions necessary for cell survival such as organelle transport and centrosome assembly. TCTEX1 is a cytoplasmic dynein light chain found in a complex with Na+ CP type X (SCN10A). TCTEX1D3, also called TCTE3, has been identified as a gene responsible for congenital diaphragmatic hernia (CDH). |
|
Applications: |
ELISA, IHC |
|
Name of antibody: |
TCTE3 |
|
Immunogen: |
Full length fusion protein |
|
Full name: |
t-complex-associated-testis-expressed 3 |
|
Synonyms: |
TCTEX1D3 |
|
SwissProt: |
Q8IZS6 |
|
ELISA Recommended dilution: |
5000-10000 |
|
IHC positive control: |
Human thyroid cancer |
|
IHC Recommend dilution: |
20-100 |
購物車
購物車 幫助
幫助
 021-54845833/15800441009
021-54845833/15800441009
